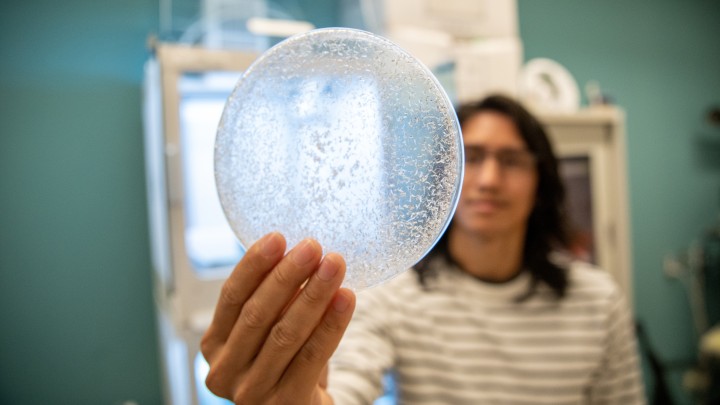
Header Image

Dr. Garth Ilsley, in Prof Nicholas Luscombe’s Genomics and Regulatory Systems Unit at OIST and Assistant Professor Angela DePace at Harvard Medical School succeeded in modelling early regulation of development in the fruit fly Drosophila using a statistical approach that accurately predicts gene expression in the whole embryo. This study was published in the open access journal, eLIFE, on August 6th.
This figure is comparison of calculated results from the model (upper half) with image data from an actual embryo (lower half). It can be seen that the mutations in stripes 3 and 7 due to the misexpression of kni (A) and hb (B) are consistent. (A) Misexpression of kni is seen as a thinner stripe 3, and stripe 3 is also cut when there are 2 copies of the transgene. (B) Misexpression of hb results in bulging, bending and cutting of stripe 3. Stripe 7 bulges when there are 2 copies of the transgene. Stripe 2 remains unaffected in both cases.